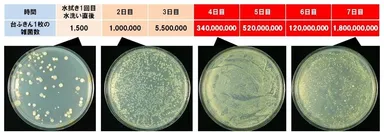
調査結果グラフ

≪食卓の衛生管理 実験レポート≫ 食中毒が気になる季節。キッチン・食卓の衛生管理を見直そう! 食卓の水拭き、室内干しを繰り返している台ふきんは、 2日目以降は100万個以上、4日目以降は1億個以上の雑菌まみれ!?
食卓や調理台を拭くなら、ティッシュペーパーやキッチンペーパーを使った アルコール除菌拭きが衛生的!
調査・報告
2014年6月24日 11:00 アルコール除菌 ラボ@キッチン&食卓(事務局:東京都渋谷区)では、2014年4月に衛生微生物研究センターと共同で、台ふきんと食卓の雑菌汚染に関する実験を行いましたので、その結果を発表いたします。
■背景
梅雨や夏になると気になるのが雑菌の繁殖です。当研究所が特に注目しているのが、多くの家庭で行われている台ふきんによる水拭きです。当研究所では、今年4月に、多くのご家庭で日常行われている「台ふきんのシンク脇での室内干し」を行うと、室内干しをした台ふきんに残った雑菌が、時間の経つごとにどうなるのかを調べました。
その結果、台ふきんをシンク脇で室内干しすると、半日経過しても台ふきんに残っていた雑菌が増殖を続けていました。
一般的なご家庭では、台ふきんの除菌方法として、1週間に1回程度、熱湯に浸したり、漂白剤を使用して除菌を行っているご家庭が多いと思われます。そこで、今回は、そのような家庭を想定し、1週間台ふきんを繰り返し使用して、雑菌がどのように増えているのかを調べました。
■実験内容
(台ふきんの使い方)
清潔な台ふきんで、食事後を想定した食べカスなどが付着している食卓を水拭きする。
台ふきんを水道水でもみ洗いし、水を絞った上で、梅雨時を想定した気温25℃、相対湿度75%の室内環境で干す。同じ台ふきんを使い、食卓の水拭き・水洗い・室内干しを朝夕2回、6日間繰り返す。
(雑菌の採取のタイミング)
1日目は、最初に食卓を水拭きして、台ふきんを水洗いした直後に採取・計測。
2日目以降は、毎朝、台ふきんを使用する直前の乾いた状態の時に採取・計測。
■調査結果
<2日目・3日目の台ふきんからは、100万個以上の雑菌を検出。
4日目以降になると、常に1億個以上の雑菌が繁殖。18億個を検出した日も。>
食卓の水拭き・水洗い・室内干しを朝と夕方に行った2日目の朝の台ふきんからは、100万個の雑菌を検出しました。4日目以降になると、毎日1億個以上の雑菌を検出。中には、18億個の雑菌を検出した日もありました。
▼調査結果グラフ
http://www.atpress.ne.jp/releases/47865/img_47865_1.jpg
<7日目の朝の台ふきんで、食卓を水拭きすると76,000個/10平方センチメートルの雑菌が食卓に付着>
食卓の水拭き後、水洗いと室内干しを朝夕6日間繰り返した7日目の朝の台ふきんで、消毒をした清潔な食卓(菌数:検出限界以下)を水拭きしました。すると、76,000個/10平方センチメートルの雑菌が食卓に付着しており、食卓をきれいにするどころか、雑菌を広げてしまう結果となりました。
▼6日間継続使用した台ふきんで水拭き後に食卓から採取した雑菌
http://www.atpress.ne.jp/releases/47865/img_47865_2.jpg
食卓の水拭き・水洗い・室内干しを6日間朝夕繰り返した台ふきんで食卓を水拭き後に食卓表面から採取した雑菌
※食卓の雑菌を32±1℃で48時間培養したもの
■清潔な環境への提案
食卓や調理台を拭く際は、きちんと除菌し乾燥した台ふきんを使いましょう。さらに簡単・手軽にすませたい方には、ティッシュペーパーやキッチンペーパーを使った“アルコール除菌拭き”をおすすめします。使い捨てなので衛生的で、しかも高濃度アルコールが、水拭きしただけでは取りきれない菌まで除去し、食卓、調理台を清潔にします。
なお、7日目の台ふきんによる水拭きで76,000個/10平方センチメートルの雑菌が付着している食卓を、ティッシュペーパーでアルコール除菌拭きしたところ、食卓表面上の雑菌数は検出限界以下となり、除菌がしっかりできていることを確認しました。食卓や調理台を拭くなら、ティッシュペーパーやキッチンペーパーを使ったアルコール除菌拭きが衛生的です。
アルコール除菌 ラボ@キッチン&食卓では、主婦の皆さまがご家庭で安心して楽しい食卓を囲めるように、アルコール除菌による清潔なキッチンの環境作りを推進してまいります。
■『アルコール除菌 ラボ@キッチン&食卓』とは
アルコール除菌 ラボ@キッチン&食卓は、一般家庭のキッチンや食卓における衛生意識を高め、清潔なキッチンのためのアルコール除菌の実践方法を伝えていくことを目的に設立された研究所です。梅雨や夏は食べ物が傷みやすく、食中毒の話題も多くなり、特に細菌性食中毒の発生件数は夏場ピークを迎えます。当研究所では、こうした時期に、ウェブサイトを通じ、アルコール除菌スプレーの使い方をはじめ、キッチンや食卓の衛生管理に役立つ様々な情報を発信しています。
URL : http://alcohol-jokin.com/
対応端末: PC/スマートフォン
<主なコンテンツ>
(1) アルコール除菌 ラボ@キッチン&食卓とは
アルコール除菌の実践方法やアルコール除菌活用のメリット、当研究所の活動目的などを紹介
(2) プロも実践!アルコール除菌
料理研究家や家事アドバイザー、飲食店などキッチンの衛生管理を徹底的に行っている方々の雑菌対策・アルコール除菌の活用術を紹介
(3) キッチン&食卓の雑菌研究室
・雑菌繁殖movie:雑菌の繁殖する様子や高濃度アルコール除菌剤によって雑菌の活動が止まる様子を紹介
・研究レポート:衛生微生物研究センターと共同で行った各種調査、実験結果を公開
(4) ニュースリリース
アルコール除菌 ラボ@キッチン&食卓の最新の情報をお知らせ
(5) お役立ちリンク
食品衛生管理や食中毒予防についてのお役立ちリンク集
■実験協力:衛生微生物研究センターについて
衛生微生物研究センター(所長:李 憲俊 所在地:東京都葛飾区)は、汚染微生物分析試験、保存効力試験(チャレンジテスト)、微生物限度試験、抗菌抗カビ試験、カビ抵抗性試験、最小発育阻止濃度(MIC)試験、空中浮遊微生物分析試験、一般生菌数測定試験、消臭試験、その他の微生物関連試験などを行っている民間の研究機関です。